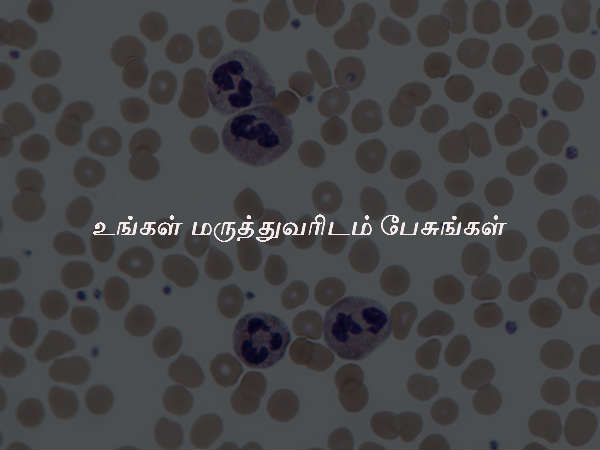
உங்கள் மருத்துவரிடம் பேசுங்கள்
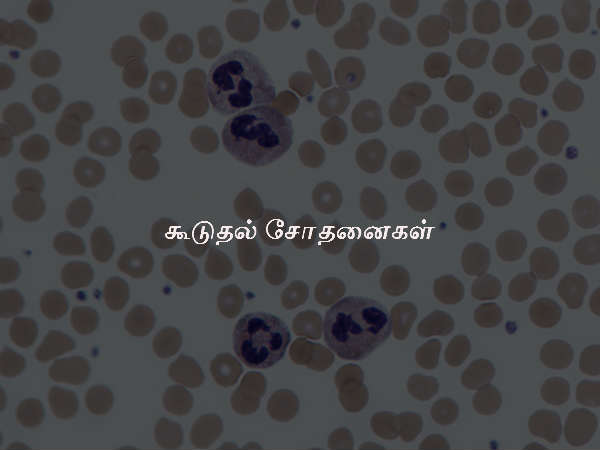
கூடுதல் சோதனைகள்
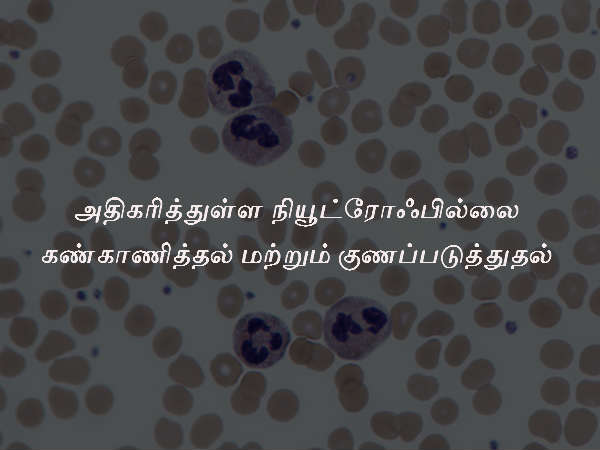
அதிகரித்துள்ள நியூட்ரோஃபில்லை கண்காணித்தல் மற்றும் குணப்படுத்துதல்

Latest Updates
-
தக்காளி சட்னி அரைக்கும் போது இந்த ஒரு பொருளை சேர்த்து அரைச்சு பாருங்க - ஆரோக்கியமாவும், சுவையாவும் இருக்கும் -
முகத்தில் உள்ள கருமையைப் போக்கணுமா? அப்ப கடலை மாவு வெச்சு இப்படி ஃபேஸ் பேக் போடுங்க.. -
இன்டர்நெட் வசதியே இல்லாத உலகின் மிகவும் மோசமான நாடு எது தெரியுமா? இங்க தங்கத்தை விட இன்டர்நெட் காஸ்ட்லி -
1 கப் கோதுமை மாவு இருந்தா.. ஈவ்னிங் டைம்-ல இந்த ஸ்நாக்ஸை செஞ்சு குடுங்க... -
இந்த 4 மாதத்தில் பிறந்தவர்கள் பணத்தை அலட்சியமாக தண்ணீர் போல செலவழிப்பார்களாம் - உங்க பிறந்த மாதம் என்ன? -
சிம்ம ராசிக்கு செல்லும் சுக்கிரன்: ஜூலையில் இந்த 3 ராசிக்கு ஜாக்பாட் அடிக்கப்போகுது... -
சாணக்கிய நீதி படி ஒரு நல்ல குடும்பத் தலைவரிடம் இருக்க வேண்டிய 4 குணங்கள் இதுதான் - உங்ககிட்ட எத்தனை இருக்கு? -
1/2 கப் பாசிப்பருப்பு இருந்தா.. இப்படி குழம்பு வையுங்க.. சாதத்துக்கு செமயா இருக்கும்.. -
இந்தியாவிலுள்ள இந்த கிராமத்திற்குள் இந்தியர்களே நுழையக்கூடாதாம் - இது எந்த நாட்டுக்கு சொந்தம் தெரியுமா? -
ஜூன் 22-ல் உருவாகும் திரிகிரக யோகம்: இந்த 3 ராசிக்கு தொழிலில் நல்ல வளர்ச்சியுடன், லாபமும் கிடைக்கும்..
உடலில் நியூட்ரோஃபில்ஸ் அளவுக்கு அதிகமானால் என்ன ஆகும் என்று தெரியுமா?
நியூட்ரோஃபில்ஸ் என்பது ஒரு வகையான ரத்த அணுக்களின் வகையாகும்.. இதை கொண்டு தான் உங்கள் உடல் தொற்றுக்களை எதிர்த்து போராடும். தொற்றின் காரணமாக தான் நியூட்ரோஃபில் அளவுகள் அதிகரிக்கும். இது போக இதர மருத்துவ நிலைகள் மற்றும் குறிப்பிட்ட சில மருந்துகளாலும் கூட இது ஏற்படலாம்.
உடல் ரீதியான அல்லது மன ரீதியான அழுத்தம், புகைப்பிடிக்கும் பழக்கம் போன்ற காரணங்களாலும் கூட நியூட்ரோஃபில் அளவுகள் அதிகரிக்கும். நியூட்ரோஃபில் அளவுகள் அதிகமாக இருக்கையில் எந்த ஒரு தீவிர பிரச்சனையையும் சுட்டிக்காட்டாது. உங்களின் நியூட்ரோஃபில் அளவு அல்லது எண்ணிக்கை அதிகமாக இருக்கிறது என மருத்துவர் கூறினால் அவரிடம் கலந்தாலோசிக்க வேண்டும்.

அதிகரித்த நியூட்ரோஃபில் அளவுகளுக்கு பின்னான வழக்கமான படிகள்
பொதுவாக, அதிகரித்த நியூட்ரோஃபில் அளவுகளின் தனிமைப்படுத்தப்பட்ட நிகழ்வுகள் ஆபத்தை ஏற்படுத்துவதில்லை. பல நேரங்களில், தானாகவே இந்த அளவு கொஞ்சம் கொஞ்சமாக இயல்பு அளவுக்கு வந்துவிடும். அப்படிப்பட்ட சூழ்நிலையில் இதற்கென எந்த ஒரு சிகிச்சையும் தேவைப்படாது. உங்கள் நியூட்ரோஃபில் அளவுகள் இயல்பு நிலைக்கு திரும்பிவிட்டதை உறுதி செய்ய, மீண்டும் ஒரு இரத்த பரிசோதனையை மேற்கொள்ள மருத்துவர் பரிந்துரைப்பார்.
உங்கள் மருத்துவரிடம் பேசுங்கள்
உங்கள் நியூட்ரோஃபில் அளவுகள் அதிகமாக இருந்தால், உங்கள் மருத்துவ வரலாற்றை உங்கள் மருத்துவர் கேட்பதற்கு வாய்ப்புகள் உள்ளது. அப்படிப்பட்ட சூழ்நிலையில் நீங்கள் எடுத்து வரும் மருந்துகளைப் பற்றி தவறாமல் உங்கள் மருத்துவரிடம் தெரிவித்து விடுங்கள். குறிப்பாக ஸ்ட்டீராய்டுகள் உங்களின் நியூட்ரோஃபில் அளவுகளை அதிகரிக்கக்கூடும். மேலும் சமீபத்தில் நீங்கள் ஏதேனும் நோய்வாய்பட்டீர்களா அல்லது ஏதேனும் உடல் ரீதியான அல்லது மன ரீதியான அழுத்தத்திற்கு உள்ளானீர்களா என்பதையும் உங்கள் மருத்துவரிடம் கூறி விடுங்கள். ஏன், இரத்த பரிசோதனை எடுக்கப்படும் நாளன்று காலையில் விடாமல் ஓடுவதாலும் கூட உங்கள் நியூட்ரோஃபில் அளவுகள் அதிகரிக்கலாம். கர்ப்பமாக இருந்தாலோ அல்லது ஏதேனும் தோற்று இருந்தாலோ அல்லது ஏதேனும் உடல் ரீதியான காயங்கள் இருந்தாலோ கூட, உங்கள் நியூட்ரோஃபில் அளவுகள் அதிகரிக்கும். நீங்கள் புகைப்பிடிக்கும் பழக்கத்தை கொண்டவரானால் கண்டிப்பாக அந்த பழக்கத்தை கைவிடுமாறு உங்கள் மருத்துவர் பரிந்துரைப்பார்.
கூடுதல் சோதனைகள்
மீண்டும் எடுக்கப்படும் இரத்த பரிசோதனையில் நியூட்ரோஃபில் அளவு குறையவில்லை என்றாலோ அல்லது ஏதேனும் ஒரு நிலை தான் இந்த நியூட்ரோஃபில் அளவு அதிகரிப்பதற்கு காரணமாக உள்ளது என்று மருத்துவர் சந்தேகித்தாலோ, கூடுதல் சோதனைகளை மேற்கொள்ள உங்கள் மருத்துவர் பரிந்துரைப்பார். இதனால் நியூட்ரோஃபில் அளவு ஏன் அதிகரிக்கிறது என்பதை புரிந்து கொள்ளலாம். பல்வேறு தரப்பட்ட தொற்றுக்கள், அழற்சி நிலைகள் மற்றும் சில புற்று நோய்களுக்காக குறிப்பிட்ட இரத்த சோதனை மேற்கொள்ளப்படும்.
அதிகரித்துள்ள நியூட்ரோஃபில்லை கண்காணித்தல் மற்றும் குணப்படுத்துதல்
நியூட்ரோஃபில் அளவை அதிகரிக்கும் பின்னணியை நீங்கள் கண்டறிந்து விட்டால், அந்த நிலையை பொறுத்து, அதற்கான சிகிச்சைகள் பரிந்துரைக்கப்படும். உங்கள் நியூட்ரோஃபில் அளவு தொடர்ந்து அதிகரித்த நிலையிலேயே இருந்தால், நியூட்ரோஃபில் அளவை மீண்டும் பரிசோதிக்க, சீரான இடைவேளையில் இரத்த சோதனை மேற்கொள்ள உங்கள் மருத்துவர் பரிந்துரைப்பார்.



Click it and Unblock the Notifications